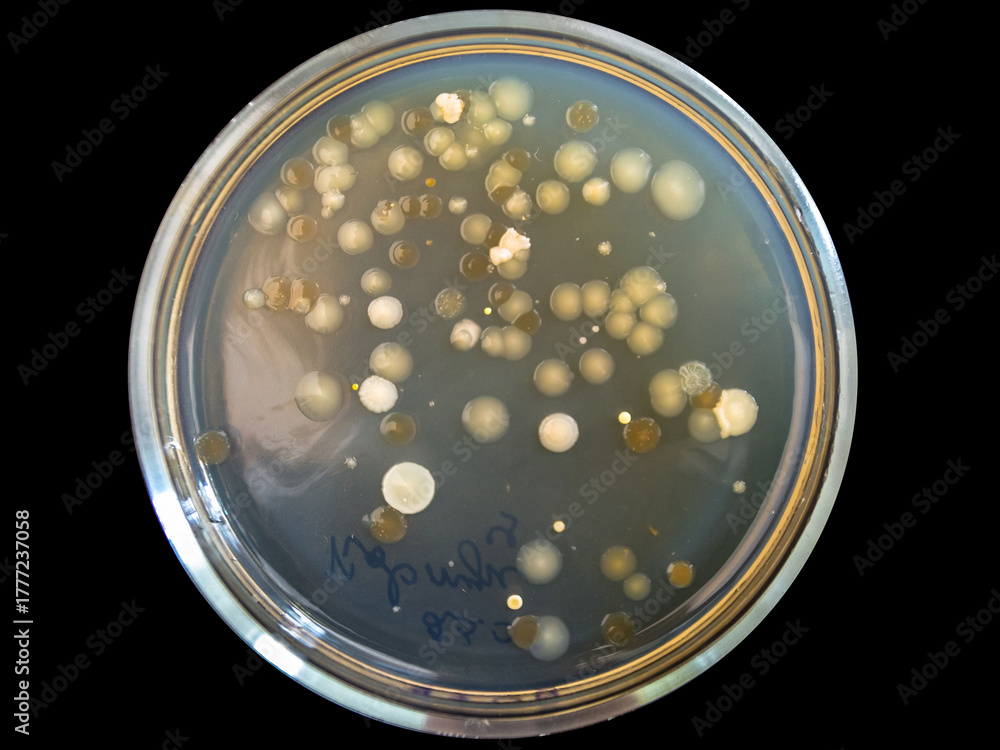

-
Značky & Merch
- Filmové plakáty
- Batman
- Spider-Man
- Star Wars
- Harry Potter
- MARVEL
- DISNEY
- Pokémon
- Zobrazit vše
- Hudební plakáty
- Queen
- Rolling Stones
- AC/DC
- Beatles
- Bob Marley
- Iron Maiden
- Metallica
- Zobrazit vše
- Anime & Manga
- Útok titánů
- Pokémon
- Demon Slayer
- Jujutsu Kaisen
- Death Note
- Dragon Ball Z
- My Hero Academia
- Zobrazit vše
- Komiksy
- Batman
- Spider-Man
- Superman
- Captain America
- Avengers
- MARVEL
- Wonder Woman
- Zobrazit vše
- Herní plakáty
- Assassin's Creed
- Nintendo
- Playstation
- Online hry
- Xbox
- Minecraft
- Sonic
- Zobrazit vše
- Obrázky pro děti
- Harry Potter
- Minecraft
- Lilo & Stitch
- DISNEY
- Ledové království
- Mickey Mouse
- Princezny
- Zobrazit vše
-
Ilustrace
- Dle motivu
- Abstraktní ilustrace
- Black & White tóny
- Cestovatelské plakáty
- Citáty a texty
- Dotek přírody
- Koláže
- Line Art
- Man Cave
- Móda
- Motivy pro děti
- Romantika & láska
- Sportovní ilustrace
- Magazine Cover
- Women Power
- Zvířata
- Inspirace pro váš dům, byt či kancelář
- Dle stylu
- Bauhaus
- Eko styl
- Retro & Vintage
- Asijská atmosféra
- Skandinávský minimalismus
- Art Deco styl
- Boho styl
- Pařížská elegance
- Tropický ráj
- Pop Art styl
- Provence styl
- Harmonie & Klid
- Romantický zámecký styl
- Industriální styl
-
Obrazy
- Obrazy na plátně
- Obrazy na plátně
- Vícedílné obrazy
- Obrazy na plátně -60 %%
- Obrazy na plátně - Trending
- Zobrazit vše
- Obrazy
- Fotoobraz na plátně
- Obrazové reprodukce
- Rámování - Rámy a lišty
- Vícedílné obrazy
- Zarámované plakáty -20 %%
- Obrazové reprodukce
- Florent Bodart
- Paul Cézanne
- Claude Monet
- Pierre-Auguste Renoir
- Sam Toft
- Leonardo da Vinci
- Alfons Mucha
- Hieronymus Bosch
- Gustav Klimt
- Wassily Kandinsky
- Leonetto Cappiello
- Vincent van Gogh
- Kacušika Hokusai
- Zobrazit vše
-
Fotografie
- Fotografie
- Tisk vlastních fotek
- Nejprodávanější
- TOP Fotografie
- Trending
- Umělečtí fotografové
- Zobrazit vše
- Fotografie dle motivu
- Černobílá elegance
- Zvířata
- Příroda & krajina
- Cesta kolem světa
- Důkaz lásky
- Každodenní momenty
- Makro
- Exotické dobrodružství
- Minimalismus
- Old school
- Panorama
- Svět chutí
- Volání hor
- Pohled z výšky
-
Plakáty
- Rámování - Rámy a lišty
- Skladové rámy
- Lišty na plakáty
- Příslušenství
- Dekorace na zeď
- Cedule
- Sada plakátů
- Plakáty a tapety na dveře
- Samolepky na nábytek
- XXL plakáty
- Panorama
- Zarámované plakáty -20 %%
- Značky & Merch
- Filmové plakáty
- Hudební plakáty
- Anime & Manga
- Komiksy
- Herní plakáty
- Obrázky pro děti
- Sporty
- Celebrity
- Plakáty
- Nejoblíbenější - TOP
- Novinky
- Tisk vlastních fotek
- Značky & Merch
- Poslední kusy -60 %%
- Výprodej až -80 %%
- Dekorace na zeď
- Rámování - Rámy a lišty
- Motivy
- Abstraktní umění
- Architektura
- Auto - Moto - Aero
- Celebrity
- Cestování
- Erotické & Sexy plakáty
- Fantasy & Mystery
- Historie & Náboženství
- Ilustrace
- Jídlo a pití
- Mapy na zeď
- Motivační plakáty & Citáty
- Móda
- Naučné plakáty pro školy
- Obrazové reprodukce
- Pro firmy
- Párty, Oslavy, Svátky
- Příroda & Krajina
- Romantika & láska
- Sporty
- Světové metropole & Města
- Vesmír
- Vlajky
- Vtipné plakáty
- Zvířata
- Černobílé plakáty - Black & White
-
Fototapety
- 3D fototapety
- Vzory a potisky
- Fototapety do dětského pokoje
- Fototapety do pokoje teenagera
- Fototapety do ložnice
- Fototapety do obývacího pokoje
- Fototapety do pracovny
- Fototapety do předsíně
- Fototapety do kuchyně
- Fototapety do koupelny
- Fototapety -60 %%
- Fototapety - trending
- Nejprodávanější
- Samolepky
- Výběr designéra
-
3D fototapety
-
Vzory a potisky
- Fototapety do dětského pokoje
- Fototapety do pokoje teenagera
- Fototapety do ložnice
- Fototapety do obývacího pokoje
- Fototapety do pracovny
- Fototapety do předsíně
- Fototapety do kuchyně
- Fototapety do koupelny
- Fototapety -60 %
- Fototapety - trending
- Nejprodávanější
- Samolepky
-
Filmové fototapety
- Výběr designéra
-
Fototapety dle motivu
- Zobrazit vše
-
 Motivy pro děti
Motivy pro děti
 Mapy světa
Mapy světa
 Příroda & Krajina
Příroda & Krajina
-
Hrnky & Nádobí
- Nádobí
- Dózy & krabičky na jídlo
- Láhve
- Otvíráky na lahve
- Podtácky
- Skleničky
- Panáky a placatky
- Talíře & Misky
- Konvice na čaj
- Nádobí dle motivu
- Anime nádobí
- Nádobí Auto Moto
- Retro nádobí
- Nádobí slavných umělců
- Fantasy nádobí
- Film & TV nádobí
- Herní nádobí
- Nádobí pro děti
- Hudební nádobí
- Komiksové nádobí
- Vtipné nádobí
- Novinky
-
Oblečení
- Oblečení
- Mikiny & Svetry
- Čepice & Kšiltovky
- Zimní oblečení
- Ponožky
- Kalhoty
- Pyžama a doplňky na spaní
- Župany & ručníky
- Tašky & Batohy
- Peněženky
- Šperky & beauty doplňky
- Deštníky
- Herní rukávy
- Spodní prádlo
- Novinky
- Trička & Topy
- Trička dámská
- Trička pánská
- Trička dětská
- Trička – Naše kolekce
- Tričko s vlastní fotkou
- Trička -60 %%
- Trička - Trending
- Trička podle značek
- Hudební trička
- Anime trička
- Filmové & TV trička
- Herní trička
- Harry Potter
- Star Wars
- Pán prstenů
- MARVEL
- Batman
- Trička podle motivu
- Trička s motivy slavných umělců
- Trička s motivy sportů
- Abstraktní trička
- Trička s asijskými motivy
- Trička Line Art
- Trička jídlo & pití
- Trička se zvířaty
- Trička Auto Moto
- Trička s dětskými motivy
- Trička s vlajkami
- Trička se značkami a piktogramy
- Vtipná trička
- Trička s citáty
- Bauhaus trička
- Pop-Art trička
- Podpora Ukrajiny
-
Trička & Topy
- Mikiny & Svetry
-
Čepice & Kšiltovky
-
Zimní oblečení
- Ponožky
- Kalhoty
- Pyžama a doplňky na spaní
- Župany & ručníky
-
Tašky & Batohy
-
Peněženky
-
Šperky & beauty doplňky
- Deštníky
- Herní rukávy
-
Oblečení dle motivů
-
Oblečení pro:
- Spodní prádlo
- Novinky
- Zobrazit vše
-
 Trička – Naše kolekce
Trička – Naše kolekce
 Trička dámská
Trička dámská
 Trička pánská
Trička pánská
 Hudební trička
Hudební trička
 Filmové & TV trička
Filmové & TV trička
 Herní trička
Herní trička
-
Dárky & Hry
- Dárky & Hry
- Dárkové poukazy
- Fotodárky
- Hračky
- Ideální dárky pro
- Vánoce
- Dárky pro muže
- Dárky pro ženy
- Dárky pro děti
- Dárky pro páry
- Dárky pro sběratele
- Dárky pro školáky
- Dárky pro mazlíčky
- Merch
- Bytové doplňky
- Cedule
- Dárkové sety
- Drobné dárky
- Figurky
- Sběratelské repliky
- Hračky
- Hrnky & Nádobí
- Kalendáře 2026 -60 %%
- Kancelářské a školní potřeby
- Plechové retro dárky
- Puzzle
- Tašky & Batohy
- Zápisníky
- Malířské potřeby
- Připravujeme
- Zarámované plakáty -20 %%
- Hračky
- Panenky
- MGA's Miniverse
- LEGO -20%%
- Plyšáci
- Akční figurky a hračky
- Modely aut
- CarTuned
- Hot Wheels
- Hrací karty
- NERF
- Deskové hry
- Obrázkové kostky
-
Pro firmy
- Pro firmy
- Krása & Wellness
- Svatební studio
- Pohostinství
- Lékaři
- Naučné plakáty pro školy
- Fitness studio
- Hrdinové ulic
- Kancelář
- Odborníci & Businessmani
- B2B Partners
- Krása & Wellness
- Kosmetické studio
- Tetovací studio
- Holičství & Barbershop
- Lázně & Welness & Spa
- Kadeřnictví
- Nehtové studio
- Fitness studio
- Fitness a posilovna
- Sportovní estetika
- Sportovní ilustrace
- Automobilist
- Jóga
- Tanec
- Fotbal
- Rámy & Rámování
- Fotodárky
Fotografie ve skutečnosti neobsahuje vodoznak ani #katalogové číslo.

Barvy výsledného tisku nemusí vždy zcela odpovídat barvám na vaší obrazovce.
Fototapeta Petri dish with bacterial colonies on black background. od Prrrettty
 4.7 3 816 hodnocení
4.7 3 816 hodnocení
Vybrat další možnosti tisku
Popis produktu
Materiál:
Vliesová tapeta
- Kvalitní materiál z netkané textilie obsahující zpevňující vlákna
- Snadná aplikace – tapety se lepí za sucha, lepidlo se nanáší pouze na stěnu
- Odolné proti oděru, omyvatelné, snadná údržba
- Používáme nejmodernější značkové technologie a ekologické barvy
- Lepidlo není součástí balení
Samolepicí tapeta
- Samolepky jsou originální a multifunkční – hodí se jako plakát nebo tapeta na zeď, nebo jako samolepka na nábytek či dveře
- Snadná aplikace – jednoduše nalepujte a odlepujte, bez použití lepidla
- Nezanechává skvrny na stěně, dá se jednoduše zastřihnout nůžkami, omyvatelné vlhkým hadříkem
- Pro tisk samolepek používáme kvalitní, 100% ekologické barvy vhodné i do dětských pokojíčků
- Přečtete si více o samolepkách.
Zákaznické recenze a hodnocení

4.7 / 5
(3 816 hodnocení)
Zobrazená hodnocení pro: Fotografie
Zúčastněte se instagramové
fotosoutěže o voucher na 1000 Kč!


1. Nahrajte fotku zakoupených
produktů na váš Instagram.
2. Označte náš profil:
@posterscz_merch.
3. Vyhrajte!
Výherce losujeme každý měsíc. Držíme vám palce.
Kontakt
FAQ
O Posters
Platba a doprava
Obchodní podmínky
Reklamace a vrácení
Ochrana soukromí
Akce a slevy
Věrnostní program
Recenze od vás
Volná místa
Rámy & Rámování
Samolepky
Nabídka spolupráce
Pro autory a umělce
Pro influencery a affiliate
Pro kapely a jiné brandy
Pro partnery B2B
Tiskové služby pro firmy
Kontakt
EUROPOSTERS, s. r. o.
PO–PÁ 7:00–15:00
+420 210 440 210
Posters.cz – Tvořím svůj svět
S Posters.cz jsme na trhu již od roku 1999 a postupně jsme se stali jedním z největších prodejců plakátů, obrazů a licencovaných merchandise dárků v Česku i v celé Evropě. Máme skladem ohromnou nabídku filmových, herních či sportovních plakátů všech velikostí i plný sklad originálních dárků pro zaryté fanoušky Star Wars, Harryho Pottera, komiksů či celé rodiny Warner Bros. Hrnky, figurky, puzzle i oblečení jsou totiž tím nejlepším dárkem pro všechny bez rozdílu věku či zájmů. Jestli jsi ale fanda spíš interiérového designu, tak i pak jsi tu správně! Máme vlastní tiskárny a tak fototapety, ilustrace, fotografie či umělecké reprodukce tiskneme jak na běžícím páse a dennodenně posíláme do více než 25 zemí.
© 1999–2025 Europosters, s. r. o. Všechna práva vyhrazena.
Odměňujeme věrné zákazníky!
Přihlášením souhlasíte s našimi zásadami ochrany osobních údajů..
























































 Vybráno
Vybráno












